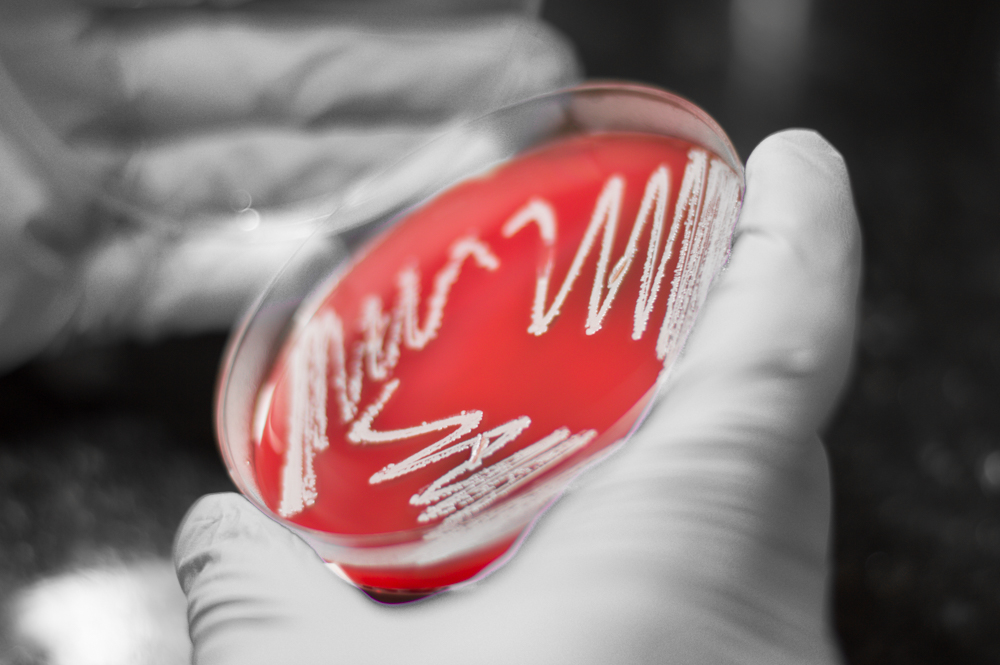

Mais notícias

CONCURSOS 2026
Acompanhe o andamentos dos concursos do IMPG.

Save the Date
O Congresso Brasileiro de Controle de Infecção e Epidemiologia Hospitalar ocorrerá 18 a 21 de novembro de 2026 no EXPOMAG, Rio de Janeiro. O evento será realizado pela AECIHERJ e ABIH.

Save the Date
CLOSTPATH 15 – 8 a 11 de setembro de 2027 – Rio de Janeiro/RJ

IMPG presente em Audiência Pública sobre acessibilidade
A Comissão de Acessibilidade e Inclusão do Instituto de Microbiologia Paulo de Góes esteve presente em Audiência Pública sobre acessibilidade na Câmara Municipal do Rio de Janeiro. Saiba mais.
Explore o IMPG

Por que fazer microbiologia?
Os microrganismos estão em todos os lugares e, por isso, a atuação do microbiologista…
Saiba mais >>

Saiba como ingressar na pós-graduação
O PPG-MICRO oferece bolsas de Mestrado e Doutorado concedidas pelos seguintes…
Saiba mais >>
Conheça nossas linhas de pesquisa
Biologia Celular, Bioquímica, Patogênese, Epideomiologia, Antimicrobianos, Aplicações Biotecnológicas, etc.
Saiba mais >>

Conheça as tecnologias desenvolvidas no IMPG
Acesse nosso portfólio de patentes e saiba como realizar parcerias.
Saiba mais >>

Conheça o Grupo de Orientação Acadêmica e Carreira (GOAC)
Criado para tirar as principais dúvidas sobre a graduação e sua carreira profissional.
Saiba mais >>

Conheça os nossos laboratórios
Explore as linhas de pesquisa e as redes sociais de laboratórios do IMPG.
Saiba mais >>

Saiba o que estamos fazendo em Extensão
Conheça nossas ações e veja como é possível integrar as atividades acadêmicas com a sociedade.
Saiba mais >>

Carta de Serviços do IMPG
Disponibilizamos, neste documento eletrônico, a Carta de Serviços ao Usuário do IMPG/UFRJ…
Saiba mais >>


















